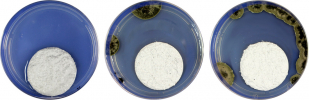
Vývoj růstu plísní v čase na omítce PCI Multiputz NoBio Z

V průběhu posledních dvaceti let se staly fasády s pastovitými omítkami naprosto běžně používanou povrchovou úpravou staveb. Na zákazníky se hrne nepřeberné množství výrobků a informací o nich. Jak se v této záplavě informací orientovat? Jak to je vlastně s těmito fasádami a jejich odolností ve skutečnosti?
Především bychom si měli říci několik technických informací, které s problematikou souvisejí. Důraz na úspory energií v posledních třiceti letech vedl logicky ke zvyšování izolačních schopností obvodových stěn a k velkému rozšíření především kontaktních zateplovacích systémů (ETICS). Jejich povrch je většinou tvořen probarvenou pastovitou omítkou. Průběh prostupu tepla takto zatepleným zdivem je však odlišný od prostupu tepla standardním cihelným zdivem. Velké tloušťky moderních izolačních materiálů (běžně přes 20 cm) s jejich nízkým součinitelem tepelné vodivosti zadrží většinu vedeného tepla v objektu. Povrch zateplovacího systému je výrazně chladnější než u standardní cihelné stěny, kde je teplo vedeno lineárně z interiéru až po omítkové souvrství. Používání velkých tlouštěk izolantů sice vede k výborným izolačním schopnostem celého souvrství, současně se však objevují některé technické a technologické problémy, které je třeba řešit.



Zvýšení tloušťky běžných izolantů nad 12 cm výrazně zvětšuje pravděpodobnost tzv. prokreslování hmoždinek na povrchu zateplené fasády. Zde se nabízí především používání talířových hmoždinek se zapuštěnou montáží a víčkem z izolantu, talířových hmoždinek s nulovým bodovým součinitelem prostupu tepla nebo injektovaných kotev s nulovým bodovým součinitelem prostupu tepla. Zcela nezbytné je dokonalé utěsnění spár mezi izolanty, a to nejlépe v celé tloušťce izolantu, minimálně však ve 2/3, aby se celková plocha izolantu chovala jako jeden celek bez tepelných a difuzních mostů. Růst tlouštěk izolantů nebo zdvojování systémů, zejména v případě MW, znamená vyšší hmotnost systému. Je třeba klást důraz na úpravu podkladu pro lepení izolantu, na kvalitu lepicích tmelů a způsob kotvení systému. U vyšších smykových sil od tíhy systému se uplatňuje princip injektovaného kotvení, které řeší přenos smykové síly od vlastní tíhy systému.
Pro investora je nejviditelnějším důsledkem používání větších tlouštěk izolantů výrazný nárůst biotického napadení povrchu zateplených fasád řasami a plísněmi. Nižší povrchová teplota zateplovacího systému vede k pomalejšímu vysychání fasády. Tento efekt se projevuje nejen při dešti, ale zejména při zvýšené vlhkosti vzduchu, kdy dochází ke kondenzaci vody na fasádě. Celoročně je množství zkondenzované vody na fasádě mnohonásobně větší než vlhkost z dešťových srážek. Pomalé vysychání této vlhkosti je jednou z hlavních příčin růstu mikroorganismů na fasádě. Pokud se k tomu přidají další investorem neovlivnitelné předpoklady, jako jsou nízké teploty v podzimních až jarních měsících, orientace fasády na sever, zvýšená koncentrace mikroorganismů vlivem blízkosti zeleně nebo vodních ploch, je pravděpodobnost poškození fasády vysoká. Vliv má také kvalita ovzduší v dané lokalitě – zlepšení kvality ovzduší paradoxně vede k většímu podílu mikroorganismů v prachových částicích, které na fasádu dopadají.

Uvedené aspekty jsou výrobcem nebo zhotovitelem neovlivnitelné. Výrobci zateplovacích systémů se proto soustředí na faktory, které ovlivnit mohou. Jde především o povrchové úpravy zateplovacích systémů, které rozhodujícím způsobem ovlivňují spokojenost zákazníků. Technologie výroby tenkovrstvých strukturovaných omítek zaznamenala v posledních dvaceti letech značný pokrok a stále se rozvíjí. Vznikají nové materiálové kombinace, které účinněji chrání fasády budov a omezují vznik a růst mikroorganismů různými způsoby. Např. omezení doby působení vlhkosti, zvýšení pH omítky nad 10, dávkování speciálními biocidními přísadami apod.
Faktor, který lze technologickým vývojem materiálů ovlivnit, je především urychlení odvodu vlhkosti z povrchu fasády. Toho lze dosáhnout buď nízkou nasákavostí (například vysoce hydrofobními povrchy), nebo zrychleným vysycháním (povrchy, které část vlhkosti rychle pojmou a díky dobré difuzní schopnosti umožní její rovnoměrné rychlé vysychání). Technologicky ovlivnitelným faktorem je také zvýšení pH omítek kombinací silikátových aditiv. Další formou ochrany povrchu může být působení fotokatalytického jevu, kdy za přítomnosti oxidu titaničitého a světelné energie vznikají radikální sloučeniny narušující organické buněčné struktury. V současnosti je jedním z nejúčinnějších způsobů ochrany fasád technologie výroby speciálních, postupně a dlouhodobě se uvolňujících biocidních přísad. Ty jsou zakomponovány v receptuře omítky a aktivně působí proti růstu mikroorganismů na povrchu fasád. Celý proces je aktivován vlhkostí na povrchu omítky.
Tato technologie je použita v prémiové tenkovrstvé omítce PCI Multiputz® NoBio Z. Jedná se o zatřenou silikonovou omítku nové generace s unikátní recepturou, která se vyznačuje vysokou ochranou proti růstu plísní a řas. Základem ochrany je obsah širokospektrálního postupně uvolňovaného, tzv. zakapslovaného biocidu Multibiotik. Tato biotická ochranná clona v kombinaci s minimální nasákavostí omítky udržuje povrch fasády dlouhodobě čistý. Vysoká paropropustnost zabezpečuje plynulý tok vodních par z fasády do exteriéru. Odolnost omítky vůči mechanickému poškození je zvýšena přítomností tří druhů vláken. Tato omítka je tónována především anorganickými pigmenty, které mají nejvyšší možnou UV stabilitu a zajišťují dlouhodobou stálost barev. Jde o volbu s nejvyšší povrchovou ochranou systémů PCI Multitherm®.
Tento krátký souhrn nevystihuje celou škálu řešení PCI pro váš dům. Vaše požadavky dovedeme odborně posoudit a najít odpovídající řešení jak v oblasti fasád, tak betonových konstrukcí, podlah i úprav interiérů. Další informace najdete na našich webových stránkách www.pci-cz.cz nebo kontaktujte nejbližšího odborného poradce PCI ve vašem okolí.
Michal Macura, produktový manažer PCI




